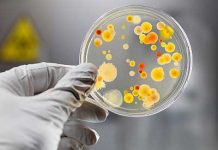
A importância dos micro-organismos no meio ambiente

Redação Pensamento Verde
A importância dos micro-organismos no meio ambiente
Micro-organismos são seres vivos de tamanho extremamente reduzido, impossíveis de serem percebidos a olho nu. Presentes no planeta há milhões de anos, povoam todas...
Anfíbios da Mata Atlântica correm risco de extinção devido às mudanças climáticas
O estudo realizado por pesquisadores do Laboratório de Biogeografia da Conservação da Universidade Federal de Goiás (UFG), divulgado na edição de fevereiro da revista...
Arena Fonte Nova é o primeiro estádio da Copa a receber a certificação LEED...
Em Salvador, na Bahia, após a última inspeção técnica realizada pela Federação Internacional de Futebol (FIFA), a Arena Fonte Nova recebeu a certificação internacional...
Designer chinês abusa da criatividade em favor da economia de água
Muitos moradores da capital paulista têm sofrido com os baixos níveis do Sistema Cantareira e, consequentemente, tiveram que aprender a racionar água. Independente do...
O desmatamento no Brasil
O desmatamento é um processo que ocorre no mundo todo, resultado do crescimento das atividades produtivas e econômicas e, principalmente, pelo aumento da densidade...
O que é corredor ecológico e a sua importância para a conservação ambiental?
O avanço da ocupação humana e também a exploração de áreas de florestas para as mais diferentes atividades econômicas acabam transformando grandes áreas verdes...